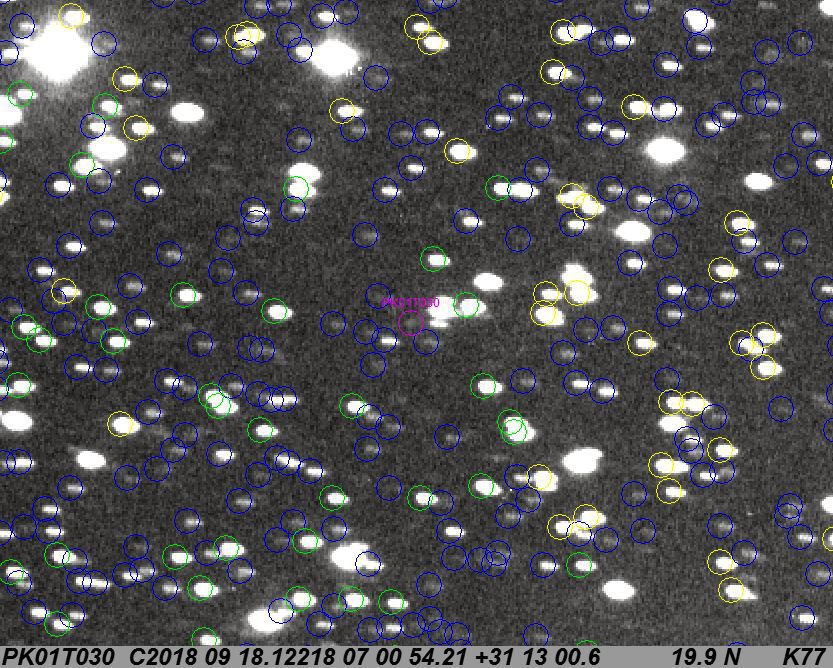

Engelhardsberg observatory
Comet 370P/NEAT
| Comet | Date | Time (UT) | Telescope | Camera |
|---|---|---|---|---|
370P |
2018-Sep-18 |
03:03 |
Newton 400mm f/2.5 |
SBIG 8300M |
| Exposure | Filter | MPC magnitude / own estimation | Motion | Binning |
4 x 5 min |
L |
19m4 / 19m9 |
52"/h |
2x2 |
Back